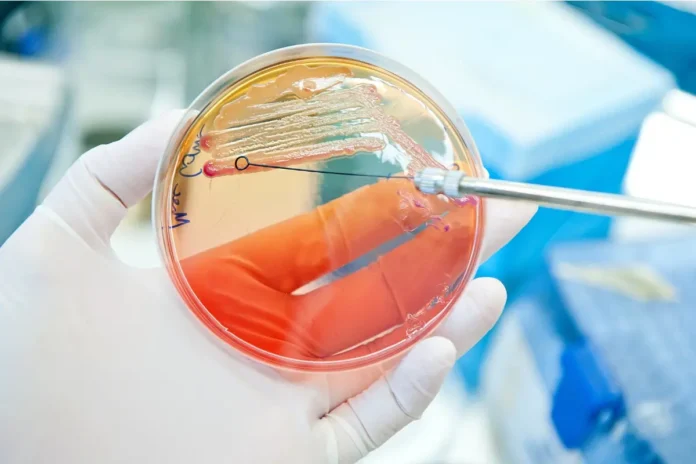

Eine Analyse aus der Steiermark zeigt deutliche Unterschiede zwischen Männern und Frauen bei der Antibiotikaresistenz von E. coli im Fall von Harnwegsinfekten. Die Ergebnisse unterstreichen, wie wichtig geschlechtsspezifische Therapieentscheidungen sind.
Daten von 2014 bis 2023 analysiert
Eine Untersuchung der Universitätsklinik für Urologie an der MedUni Graz ergab signifikante geschlechtsspezifische Unterschiede in den Antibiotikaresistenzmustern von Escherichia coli bei Harnwegsinfektionen (HWI).
Basis war eine retrospektive Analyse steirischer lokaler Resistenzberichte von 2014 bis 2023. Die Ergebnisse wurden im Rahmen des 77. Kongresses der Deutschen Gesellschaft für Urologie (DGU) Mitte September in Hamburg präsentiert.
Mehr Komplexität bei Männern, aber höhere Resistenzraten bei Frauen
Während HWI häufiger bei Frauen auftreten, sind Männer tendenziell öfter von komplizierten Verläufen betroffen. In die Studie wurden Mittelstrahl-Urinproben von Personen ab 18 Jahren einbezogen. Insgesamt analysierte das Grazer Forschungsteam über 25.000 E.-coli-positive Proben, konkret 4.400 männliche und 21.390 weibliche.
Die Analyse der Resistenzdaten ergab folgendes Bild:
- Amoxicillin/Clavulansäure: höhere Resistenz bei Männern (11,8%) im Vergleich zu Frauen (9,7 %)
- Trimethoprim/Sulfamethoxazol: höhere Resistenz bei Frauen (19,7%) als bei Männern (14,6%)
- Ciprofloxacin: 9,5% Resistenz bei Männern, 8,2% bei Frauen. Den größten Unterschied gab es 2017 (16,1% vs. 11,3%).
- Fosfomycin: insgesamt niedrige Resistenz, jedoch bei Frauen signifikant höher (0,8% vs. 0,5%;)
- Nitrofurantoin, Cefuroxim und Mecillinam: keine signifikanten Unterschiede zwischen den Geschlechtern.
Schlussfolgerungen für die Praxis
„Diese Ergebnisse unterstreichen die Notwendigkeit geschlechtsspezifischer Überlegungen bei der empirischen Auswahl von Antibiotika, um die Wirksamkeit der Behandlung zu verbessern und die Antibiotikaresistenz weiter zu reduzieren“, betont Erstautorin Dr. Anna Mangge von der Universitätsklinik für Urologie der MedUni Graz.
Nicht-antibiotische Behandlungen fördern
In der Primärversorgung gehen rund 25% der Antibiotikaverschreibungen auf das Konto von Harnwegsinfekten. Trotz einer Spontanheilungsrate von bis zu 30% würden diese in der Praxis meist antibiotisch behandelt, was wesentlich zur Problematik der antimikrobiellen Resistenz beitrage, so Mangge.
Obwohl aktuelle Leitlinien und Studien die Sicherheit und Wirksamkeit nicht-antibiotischer Behandlungsstrategien belegen, würden diese selten angewandt. Ein aktuelles Projekt der Grazer Uniklinik will deshalb die Akzeptanz gegenüber nicht-antibiotischen Behandlungsstrategien bei Harnwegsinfekten in der Primärversorgung fördern.
Dieser Beitrag könnte Sie auch interessieren:
Neue Hoffnung gegen Superbakterien: Glykopeptid Saarvienin A